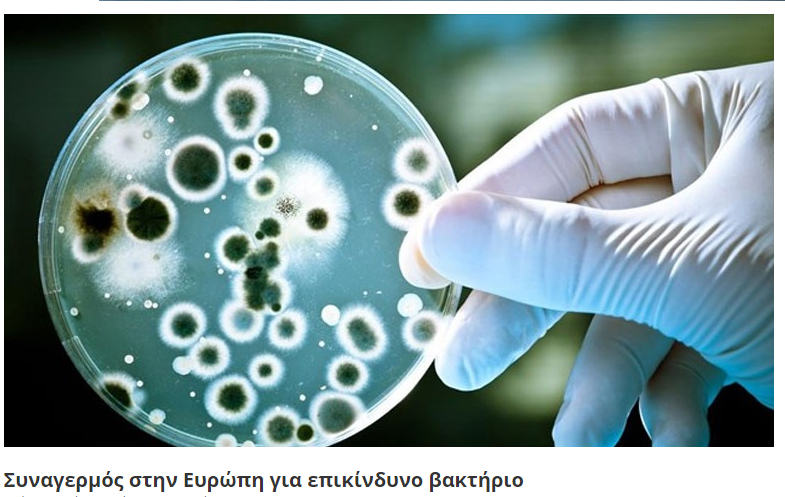

Κωνσταντίνα Παπατσάκωνα, Μάριος Βελέντζας
Αναβρασμός επικρατεί στον αγροτικό κόσμο της Ιταλίας, καθώς μεγάλες εκτάσεις με ελαιόδεντρα στο νότιο τμήμα της χώρας έχουν προσβληθεί από καταστροφικό βακτήριο, προκαλώντας μεγάλη οικονομική ζημία στους γαιοκτήμονες.
Επείγουσα δικαστική έρευνα από την εισαγγελία της Ιταλίας για τους λόγους εξάπλωσης του βακτηρίου Xylella fastidiosa, το οποίο οδηγεί σε καύση ή κοπή του ελαιόδεντρου
Η εισαγγελία αιτιολόγησε το σκεπτικό της απόφασής της να μπλοκάρει τη λήψη δραστικών μέτρων για την καταπολέμηση της επιδημίας (κάψιμο «άρρωστων» δέντρων, ψεκασμοί με εντομοκτόνα), λέγοντας ότι πολύ λίγα είναι γνωστά για την επιδημία, ώστε να λαμβάνονται τόσο «σκληρά» μέτρα.
Δηλώσεις του ευρωβουλευτή και πρώην καθηγητή Αγροτικής Οικονομίας Paolo De Castro…
Στα μαχαίρια Ρώμη – Βρυξέλλες
Παράλληλα, σε εξέλιξη βρίσκεται η κόντρα Ρώμης – Βρυξελλών για τον τρόπο αντιμετώπισης της επιδημίας, καθώς η μεν Ευρώπη απαιτεί τη λήψη δραστικών μέτρων, με την ιταλική κυβέρνηση να αναζητά εναλλακτικούς τρόπους δράσης με το λιγότερο δυνατό πολιτικό κόστος. Ήδη, η Κομισιόν έχει ζητήσει εξηγήσεις από τη Ρώμη για την καθυστερημένη αντίδρασή της σε μια -όπως υποστηρίζει- πολύ επικίνδυνη κατάσταση.
Η Κομισιόν έχει ζητήσει εξηγήσεις από τη Ρώμη για την καθυστερημένη αντίδρασή της σε μια -όπως υποστηρίζει- πολύ επικίνδυνη κατάσταση«Δεν μπορούμε να καταλάβουμε για ποιον λόγο τα ιταλικά δικαστήρια μπλόκαραν το σχέδιο αντιμετώπισης της επιδημίας» ανέφερε στις 10 Δεκεμβρίου ο Enrico Brivio, εκπρόσωπος της Ευρωπαϊκής Επιτροπής, εκφράζοντας την αβεβαιότητά του για το μέλλον και τις επιπτώσεις που μπορεί να έχει μια τέτοια στάση όχι μόνο για τις καλλιέργειες στην Ιταλία αλλά και την υπόλοιπη Ευρώπη.
«Το βακτήριο Xylella fastidiosa και τα υπόλοιπα στελέχη του είναι ίσως από τις πιο σοβαρές απειλές, με τεράστιο οικονομικό αντίκτυπο. Τα έκτακτα μέτρα πρέπει να εφαρμοστούν άμεσα» πρόσθεσε ο Ευρωπαίος αξιωματούχος.
Τι περιλαμβάνει το ιταλικό σχέδιο δράσης:
- Κόψιμο ελαιόδεντρων που έχουν προσβληθεί
- Καταστροφή των υγιών δέντρων για τη δημιουργία νεκρής ζώνης

Λαμβάνοντας υπ’ όψιν τον χρόνο που απαιτείται προκειμένου να δημιουργηθεί ένα ελαιόδεντρο και να μπορέσει αυτό να καρποφορήσει, η ζημιά είναι ανυπολόγιστη. Βάσει της ευρωπαϊκής νομοθεσίας, οι ιταλικές αρχές είναι υποχρεωμένες να προβούν σε όλες τις απαραίτητες ενέργειες προκειμένου η συγκεκριμένη ασθένεια να μην ξεφύγει από τα γεωγραφικά όρια της Κάτω Ιταλίας και εξελιχθεί σε επιδημία, που θα εξαπλωθεί σε άλλες ευρωπαϊκές χώρες, συμπεριλαμβανομένης και της Ελλάδας.
Στο μικροσκόπιο της ιταλικής Δικαιοσύνης η εξάπλωση της νόσου
Κατά τη διάρκεια συνέντευξης Τύπου στις 18 Δεκεμβρίου 2015 στο Λέτσε της Νότιας Ιταλίας, η εισαγγελία ανακοίνωσε την έναρξη άμεσης έρευνας για την ασθένεια που απειλεί το γεωργικό κεφάλαιο χιλιάδων αγροτών.
Βασικό ερώτημα αποτελεί το πως πέρασε το Xylella fastidiosa από την αμερικανική ήπειρο -όπου είναι αρκετά κοινό σε καλλιέργειες της Βραζιλίας, του Πουέρτο Ρίκο και της Καλιφόρνια των ΗΠΑ- στην Ιταλία. Παράλληλα, ανακοίνωσαν την παύση του προγράμματος καύσης και κοπής από τη ρίζα των ελαιόδεντρων που έχουν προσβληθεί, καθώς ελάχιστα είναι γνωστά για το συγκεκριμένο βακτήριο, επομένως δεν δικαιολογείται η λήψη τέτοιων μέτρων.
«Είμαστε σοκαρισμένοι. Οι κατηγορίες είναι αβάσιμες» αναφέρει ο Donato Boscia, επικεφαλής του Ινστιτούτου για τη Βιώσιμη Προστασία των Φυτών στο Μπάρι, ο οποίος συνελήφθη, κατηγορούμενος για εξάπλωση από αμέλεια της συγκεκριμένης ασθένειας η οποία προκαλεί την ξήρανση του δέντρου. Ο ίδιος κατηγορεί τις ιταλικές αρχές για παρουσίαση ψευδών στοιχείων.
Τα δύο σενάρια εισόδου
Σύμφωνα με το scientificamerican.com, η εισαγγελία προχώρησε τον Μάιο σε κατάσχεση υπολογιστών και εγγράφων από επιστημονικά κέντρα της Κάτω Ιταλίας, χωρίς ωστόσο να δώσει στη δημοσιότητα τις λεπτομέρειες που στοιχειοθετούν κατηγορίες σε βάρος των επιστημόνων.
Ανάμεσα στα σενάρια που εξετάζονται για τον τρόπο εισόδου του βακτηρίου στην Ιταλία είναι αυτό που θέλει το στέλεχος να εισήλθε από την Καλιφόρνια, κατά τη διάρκεια εκπαιδευτικού σεμιναρίου του «Mediterranean Agronomic Institute» το 2010 στο Μπάρι και στη συνέχεια απελευθερώθηκε στο περιβάλλον. Άλλη υπόθεση θέλει το βακτήριο να ήρθε μέσω της εισαγωγής καλλωπιστικών φυτών από την Κόστα Ρίκα.
Πηγή: EuroparlTV
Σε επιφυλακή οι αγροτικοί συνεταιρισμοί στην Ελλάδα
Η κατάσταση στην Ιταλία έχει προκαλέσει έντονη ανησυχία σε αγροτικές ενώσεις στην Ελλάδα και συγκεκριμένα σε περιοχές όπου υπάρχουν μεγάλοι ελαιώνες.
Η κατάσταση στην Ιταλία έχει προκαλέσει έντονη ανησυχία σε αγροτικές ενώσεις στην Ελλάδα και συγκεκριμένα σε περιοχές όπου υπάρχουν μεγάλοι ελαιώνες
Από τη μεριά του ο πρόεδρος της Ένωσης Μεσσηνίας Παναγιώτης Κατσούλης εμφανίστηκε ανήσυχος και ζήτησε την εντατικοποίηση των ελέγχων στα δενδρύλλια που εισάγονται στη χώρα από το εξωτερικό.